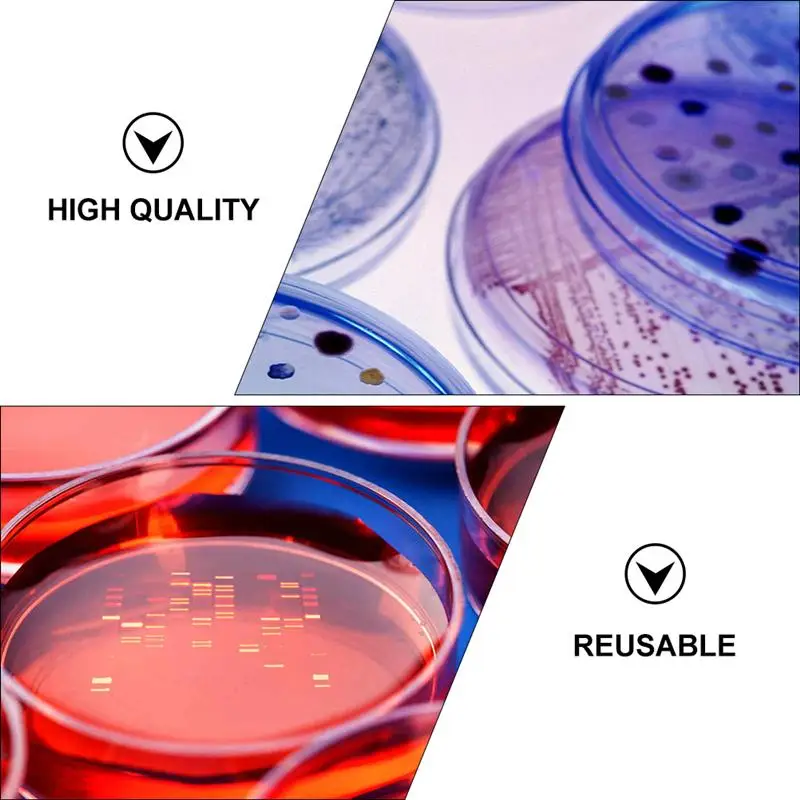

Стекло с полным покрытием для Xiaomi Redmi 12C 4G, 2 шт., закаленное стекло Redmy Radmi 12 C C12 Redmi12C 6,71 дюйма 22120RN86G, защита экрана
Price history chart & currency exchange rate
Customers also viewed

$19.58
Semi-transparent Hollow Crochet Curtains Bohemian Wind Balcony Tulle Lace Fringe Curtains Living Room Decorative Tablecloth
aliexpress.com
$1.03
Платье для выступления, костюм с крыльями, блестящими крыльями бабочки и ангела, вечерние наряды на Хэллоуин, косплей для женщин
aliexpress.com
$7.87
Women's Bikini Ethnic Style Push Up Bikini Sets Lace Split Swimsuit Bathing Suit Bottoms Lace Up Swimming Bathing Suit Female
aliexpress.com
$33.30
French Lazy Style Contrast V-neck Sweater Women's Autumn Rainbow Gradient Beautiful Knit Loose Long Sleeve Top sweater
aliexpress.com
$25.90
VOR76589,23215-64J02,2321564J02,23215-64J00,2321564J00,232150P601,88925168 Voltage Regulator For NISSAN SENTRA 93-94,ALTIMA 93-
aliexpress.com
$103.71
21596649 Car Engine Brake Control Valve Switch Coil Valve Repair Kits for VOLVO M13 Motor D13A
aliexpress.com
$781.58
Европейская кожаная кровать 1,8 м шампанское золото 2 м двойная кровать Французская Классическая резная цельная деревянная вилла спальня Свадебная кровать
aliexpress.com
$418.92
For Toyota Avanza 2019+ Electric Tailgate Control of the Trunk Drive Luggage Car Lifter Automatic Trunk Opening Rear Door Power
aliexpress.com
$3.81
Fomiyes Massagers Reflexology Mat Foot Massage Mat Acupressure Mat Foot Reflexology Walking Toe Plate Yoga Mat Outdoor Game
aliexpress.com
$14.23
Простые и эффективные способы исцеления: Исцеление звуком, словом, цветом, Быстрое восстановление здоровья, Жизнь без лекарств, Все о раке и опухолях, Исцеляющие мантры в Аюрведе (комплект из 5 книг)
chitai-gorod.ru
$5.39
Аксессуар Gembird Cablexpert DisplayPort 20M/20M 1.8m Black CC-DP-6, DisplayPort 20M/20M
pleer.ru
$61.73
women's casual / sporty athleisure tights leggings 2 in 1 elastic waist ankle-length pants leisure sports gym stretchy plain comfort mi, Black
dhgate.com
$6.28
Unisex Solid Color Foldable Bucket Hat Women Outdoor Sunscreen Cotton Fishing Hunting Cap Gorros Pescador Chapeau Femme Sombrero
aliexpress.com
$3.04
VISNXGI повседневные летние футболки для девочек женские многоцветные шорты дамы хлопок Мягкие Уютные теплые леггинсы с эластичной резинкой; ...
aliexpress.com
$20.99
2PCS/Set Seamless Fitness Women Yoga Suit High Stretchy Workout Sport Set Padded Sports Bra High Waist Sports Legging Gym
aliexpress.com
$22.53
LYEEYNNR Fake Two Piece Sweatshirts Women Ruffles Contrast Color Patchwork O Neck Hoodies Casual All-match Long Sleeve Jackets
aliexpress.com
$11.72
Женская сумка-тоут с градиентом FORUDESIGNS, 2 шт., модная дорожная Роскошная вместительная сумка с Полинезийским принтом для дам
aliexpress.com
$13.42
Girls Hip Hop Clothing Green Crop Tops Pants Jazz Performance Costume Kids Hip Hop Clothes Ballroom Practice Stage Wear
aliexpress.com
$19.89
New Zigbee Smart Rotary/Touch Light Dimmer Switch Smart Life/Tuya APP Remote Control Works with Alexa Google Voice Assistants
aliexpress.com
$9.58
Nordic Style Wall Mounted Hanging Wooden Iron Storage Rack Living Room Storage Shelf Organizer Mesh Basket Wall Decoration
aliexpress.com
$15.10
DC Power Jack Charging Port in Cable Harness for Lenovo ALL IN ONE A540 A740 tbs
aliexpress.com
$38.98
Simulation Flame Lamp Stove Desktop Hanging Fireplace Pendulum Holidays Party Home Decorative Light
aliexpress.com
$33.03
4PCS 120cm AC85-265V LED Surface Mount Lights 2835SMD LED Batten Linear Tube Light for Office Supermarket Home
aliexpress.com
$11.60
16PCS Chip Clips Plastic Bag Sealer Stick, Stay Fresh Bag Sealer Sticks Magic Kitchen Food Storage Clips, Bag Sealer
aliexpress.com
$11.78
Electric Mosquito Swatter Killer USB Photocatalyst Rechargeable Mosquito Insect Racket Trap Household Electric Fly Bug Zapper
aliexpress.com
$18.11
Pet Dog Super Absorbent Bath Towel Dog Bathrobe Pet Drying Towel Microfiber Dog Cat Quick-Drying Bath Towels Sleeping Clothes #
aliexpress.com
$15.39
30pcs Transparent Useful Plastic Petri Dish Transparent Petri Dishes for Laboratory School
aliexpress.com
$30.84
COIGARSAM Short blouse women New Summer Chiffon Puff Sleeve V-Neck blusas womens tops and blouses 8012
aliexpress.com
$3.82
Elastic Face Slimming Bandage V-Line Face Slim Lift Up Belt Women Cheek Slim Lift Up Mask V Anti Wrinkle Strap Band Facial Beaut
aliexpress.com









